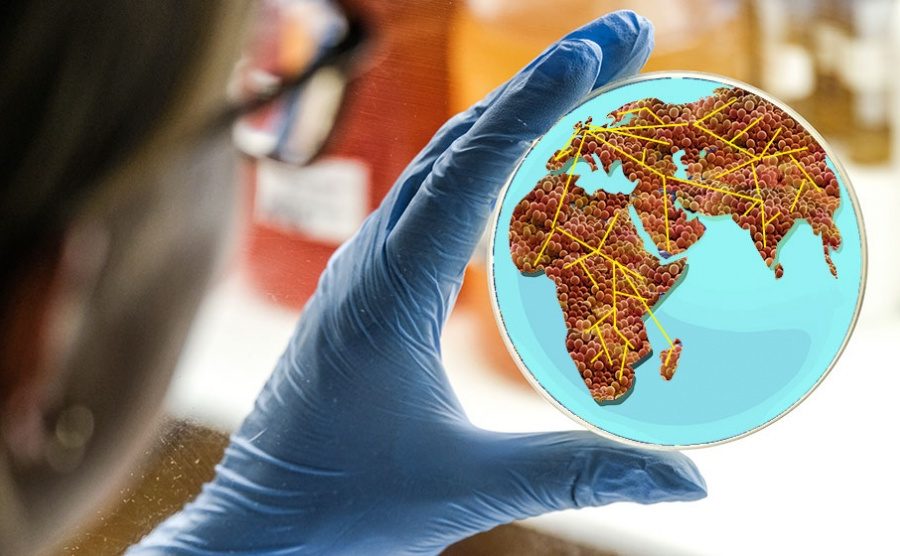

CGPS partner awarded world’s first GFGP certification

We are proud to announce that the Central Research Laboratory at Kempegowda Institute of Medical Sciences (CRL KIMS) in Bangalore, a partner in our Global Health Research Unit for Genomic…
Khalil Abudahab11 June 2020